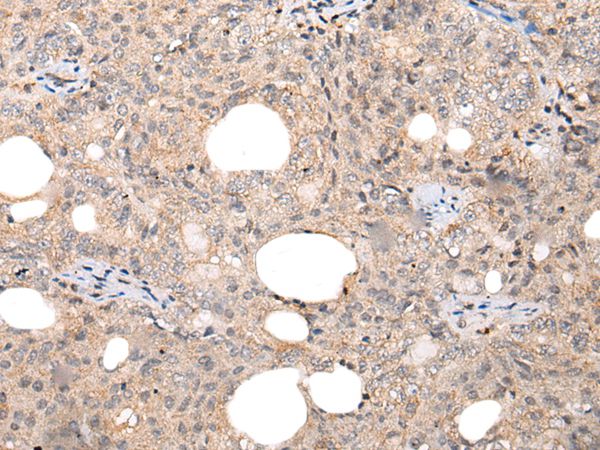

Immunohistochemical staining of human endometrium, lymph node, pancreas and small intestine using Anti-CHAMP1 antibody HPA008900 (A) shows similar protein distribution across tissues to independent antibody HPA006623 (B).
Anti-CHAMP1 Antibody
HPA008900
ApplicationsImmunoCytoChemistry, ImmunoHistoChemistry
Product group Antibodies
ReactivityHuman
TargetCHAMP1
Overview
- SupplierAtlas Antibodies
- Product NameAnti-CHAMP1 Antibody
- Delivery Days Customer4
- ApplicationsImmunoCytoChemistry, ImmunoHistoChemistry
- CertificationResearch Use Only
- ClonalityPolyclonal
- ConjugateUnconjugated
- Gene ID283489
- Target nameCHAMP1
- Target descriptionchromosome alignment maintaining phosphoprotein 1
- Target synonymsC13orf8, CAMP, CHAMP, MRD40, NEDHILD, ZNF828, chromosome alignment-maintaining phosphoprotein 1, zinc finger protein 828
- HostRabbit
- IsotypeIgG
- Protein IDQ96JM3
- Protein NameChromosome alignment-maintaining phosphoprotein 1
- Scientific DescriptionRecombinant Protein Epitope Signature Tag (PrEST) antigen sequence
- ReactivityHuman
- Storage Instruction-20°C,2°C to 8°C
- UNSPSC41116161